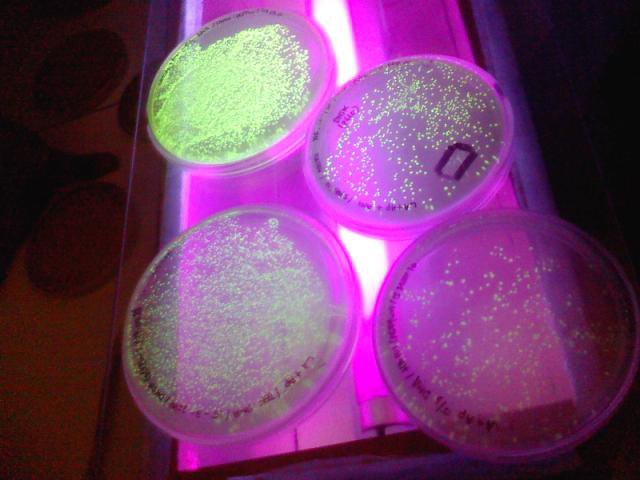

Global Media Ratings
Countries Mentioned
Country | Mentions | Sentiment | Dominance | + Persistence | x Population | = Reach | x GDP (millions) | = Power |
---|---|---|---|---|---|---|---|---|
Brazil | 1 | 5.00 | 0.04% | +0% | 211,049,527 | 88,047 | $1,500,000 | 626$ |
Switzerland | 1 | 6.00 | 0.06% | +0% | 8,654,622 | 5,509 | $700,000 | 446$ |
Slovenia | 1 | 6.00 | 0.07% | +0% | 2,078,938 | 1,539 | $56,000 | 41$ |
Totals | 3 | 221,783,087 | 95,095 | $2,256,000 | 1,113$ |
Interactive World Map
Each country's color is based on "Mentions" from the table above.
Recent Mentions
Slovenia:
Charles Hooreman exposed the counterfeit work of Bruno Desnoues by testing the authenticity of the furniture.
6
Switzerland:
Charles Hooreman, a student of Pallot, raised doubts about the authenticity of certain chairs.
6
Brazil:
Charles Hooreman, a former student of Pallot, raised suspicions about his mentor's authenticity in the art world.
5